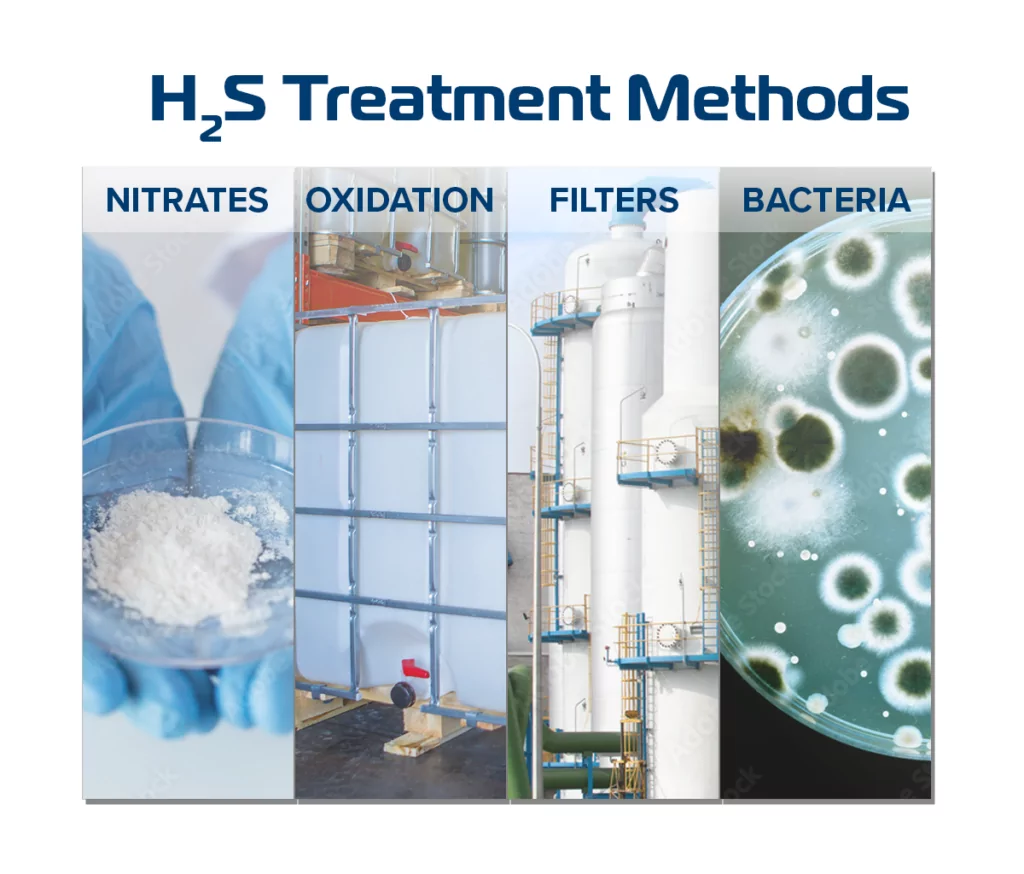

Elevated hydrogen sulfide (H2S) levels are a serious concern for wastewater operators and introduce a variety of treatment challenges. While many treatment options reduce the symptoms of H2S (odors, safety risks, and corrosion), they are reactive and neglect the underlying culprit: sulfur-reducing bacteria (SRB). A discussion of H2S generation will aid in exploring the pros and cons of common reactive H2S treatment methods and how bioaugmentation can be a proactive treatment method.
The Escalating Phases of H2S
At low concentrations, H2S exhibits a rotten egg odor. At high concentrations, H2S can cause corrosion or physical harm including loss of consciousness or death in extreme cases. Understanding how H2S is generated and changes through its breakdown cycle is crucial to making informed treatment decisions (Figure 1).
Figure 1: Sulfate breakdown in a typical wastewater environment.
The process starts with sulfate, which is often present in wastewater. Normal levels of sulfate are harmless and natural. Sludge and fats, oil, and grease (FOG) are another common component of wastewater. When combined, sludge and FOG can create a reaction which removes oxygen from wastewater and potentially creates an anaerobic environment SRB thrive in anaerobic environments with high levels of sulfate. The higher the concentration of SRB, the higher the potential for H2S production.
Most H2S treatments occur at this point in the breakdown chain, either by enhancing the non-SRB microbial community by introducing additives, or by removing H2S. If H2S goes untreated, the severity of its effect increases, potentially causing safety hazards and/or odor complaints.
If H2S remains and sulfur-oxidizing bacteria (SOB) are present, sulfuric acid may be produced. Sulfuric acid is highly corrosive and can damage concrete and metal. The further H2S breaks down in the wastewater environment, byproducts become more harmful, and treatment becomes more difficult and costly.
Common Treatment Methods
Because H2S is a routine problem for wastewater operations, there are many common treatment methods. Ideally, a treatment method:
- Prevents H2S formation
- Reduces SRB count
- Removes sulfates, sludge, and FOG
Below is a discussion of common treatment methods. Several of these methods are reactive, treating H2S after it has been produced. One treatment method, bioaugmentation, is proactive, stopping H2S production before it begins.
Figure 2: Common H2S treatment methods
Nitrates
Nitrates (such as calcium nitrate) are commonly used to strengthen non-SRB microbial communities to out-compete SRB. SRB often thrive in a microbial community because of their ability to utilize sulfate as a respiration source. When other microbes are given an alternate respiration source (such as nitrate), they proliferate and consume the carbon sources that SRB otherwise would. As non-SRB microbes outcompete the SRB for resources, the amount of H2S generated is reduced.
There are drawbacks to introducing nitrates to wastewater. If enough sulfates remain in the system, nitrate cannot be dosed at high enough levels to reduce SRB levels. Nitrates also do not reduce sludge or FOG, which allows anaerobic environments to persist. If the anaerobic environment is not changed, SRB will also persist, and require continuous treatment.
Oxidizers
As SRB break down sulfate, the oxygen is removed from the compound. Oxidizers are implemented at wastewater facilities to reintroduce oxygen and break H2S down to sulfate and water. The oxidation process takes H2S from the air or wastewater and amends it with oxygen.
There are drawbacks to using oxidizers to reduce H2S concentrations. The amount of oxidizer applied to reduce H2S is high, especially if used for both aqueous and gaseous applications. Oxidizer dosing requires expensive infrastructure as well. Sludge and FOG is not reduced by oxidization, allowing anaerobic environments (and therefore SRB) to persist and require continuous expensive treatment.
Scrubbers and Filters
Scrubbers and filters are an addition to a wastewater system to remove contaminants such as H2S. Scrubbers can chemically neutralize H2S and filters physically remove unwanted components. Once removed, the byproducts are stored in silos. This is a reactive method to reduce H2S, and it requires large infrastructure costs while failing to preventatively interact with any of the steps of H2S formation. On top of this, once the H2S has been collected, it still needs to be dealt with, leading to more maintenance and removal costs.
There are drawbacks to scrubbers and filters in wastewater treatment systems. Expensive infrastructure for both the scrubber and filters system itself and the storage units must be built and maintained. The materials removed and stored are potentially hazardous and must be disposed of. As with nitrate and oxidizer treatment, scrubbers and filters do not remove sludge and FOG. If these persist, the anaerobic environments (and therefore SRB) also persist and require continuous treatment.
Bioaugmentation
Bioaugmentation is the process of adding microorganisms to wastewater to enhance the microbial environment allowing beneficial bacteria to out-compete harmful bacteria, such as SRB. These bacteria are specifically selected to treat a problematic wastewater component. In the case of H2S, beneficial bacteria are added to wastewater that compete against SRB for sulfate while digesting the carbon (in the form of sludge, FOG, and biofilms). The beneficial bacteria (a novel strain discussed below) utilizes the entire sulfate molecule without the byproduct of H2S. Bioaugmentation is the only method that not only reduces H2S, but removes SRB, sulfates, sludge, and FOG from the environment. This method can be implemented with minimal service hours and minimal infrastructure costs.
Results of Bioaugmentation
MDG’s Biotifx® products have been used to mitigate H2S in hundreds of systems domestically and internationally. Recently our technical team compiled H2S gas monitoring data prior to and during bioaugmentation treatment with Biotifx® from 20 distinct applications. All 20 data sets were from municipal collections systems to compare similar conditions, but systems ranged in geography, season, daily flow, and pre-treatment concentrations of H2S. Levels of H2S within these systems were increased due to factors such as slow gravity, long force mains, lift stations burdened with long hydraulic retention time, and FOG.
Despite varying conditions, bioaugmentation was effective in reducing H2S in 90% of field trials, and on average decreased H2S by 50% across the 20 trials. Bioaugmentation worked in low concentration scenarios where H2S presented a minor odor problem as well as in high concentration scenarios where H2S caused extreme corrosion to sewer pipes and concrete structures.
Figure 3: On average, H2S decreased by over 50% across 20 municipal wastewater systems.
To understand bioaugmentation further, three case studies are discussed below to understand how MDG’s team assisted partners in a variety of challenging situations.
Case Study #1: Extreme Levels of H2S
Flow: 3 million gallons/day
Treatment Setup: Dosed into a single lift station upstream of a 5-mile force main.
This plant was fighting corrosion and disintegration of metal and concrete components of a lift station from extremely high H2S and sulfuric acid levels, an expensive situation for the city. During initial field testing, H2S gas monitors maxed out at 350 ppm. With the use of MDG’s bioaugmentation products and onsite assistance, our partner reduced H2S from 350+ ppm to 125 ppm in 36 days. (Figure 4)
Figure 4: H2S steadily decreases after implementing bioaugmentation.
Case Study #2: Several Dosing Locations
Flow: 300,000 gallons/day
Treatment Setup: Four dosing locations leading into several force mains.
Due to heavy corrosion of lift station components and odor complaints, this client previously tried other biological treatment methods for H2S reduction without success. With the MDG bioaugmentation program, each location was appropriately dosed based on H2S concentrations and flow for downstream success. H2S was reduced by 71% at the three monitoring locations. After further monitoring and analyzing ongoing treatment results with our partner, dosing was increased at all locations which resulted in an 81% decrease in H2S. (Figure 5)
Figure 5: H2S concentrations from Case Study 2, exhibiting a decrease across all dosing locations, especially upon increased dosage.
Case Study #3: Complex System
Flow: 2 million gallons/day
Treatment Setup: Multiple force mains, 3 dosing locations
A large downstream lift station accumulated high levels of H2S gas and FOG. The facility treated FOG monthly using large volumes of calcium nitrate, incurring $360,000 in maintenance costs annually. This was an ongoing cost, since only the H2S byproducts were treated, not the H2S source itself. To solve the core problem, MDG’s expertise and bacterial products were brought on to help fix the problem. Not only did bioaugmentation reduce H2S levels to almost zero, but FOG levels were also significantly reduced (Figure 6), saving the city 94% of its previous maintenance costs. After bioaugmentation, this client has reduced its need for FOG removal (dredging) from monthly to only twice annually, significantly reducing their operational costs.
Figure 6: Large decreases in sludge after bioaugmentation significantly reduced the need for mechanical removal.
Summary
MDG began collecting this bioaugmentation data two years ago and the results have been astounding. Regardless of the water chemistry and temperature, Biotifx® decreased H2S, sludge, and odors by creating microbial communities, which also help to prevent future problems. And these were not in mild scenarios. MDG treated multiple wastewater systems that were struggling with dangerous H2S levels, successfully reducing them from over 500 ppm to under 100 ppm. In addition to being effective, bioaugmentation requires lower hours of service, zero infrastructure costs, while setting you up for success in the future. In this article, we have highlighted how Biotifx works to decrease H2S, but it works as a holistic wastewater solution, digesting sludge, reducing FOG, all factors that lead to the accumulation of H2S to begin with.
If you’re interested in our bioaugmentation product, Biotifx®, you can learn more here or contact the wastewater team.
Notes:
The municipal applications were chosen so the conditions would be similar to each other, reducing the variables in comparisons.
MDG has also conducted multiple effective field trials on industrial wastewater plants. Please contact MDG for additional case studies and information regarding industrial applications.